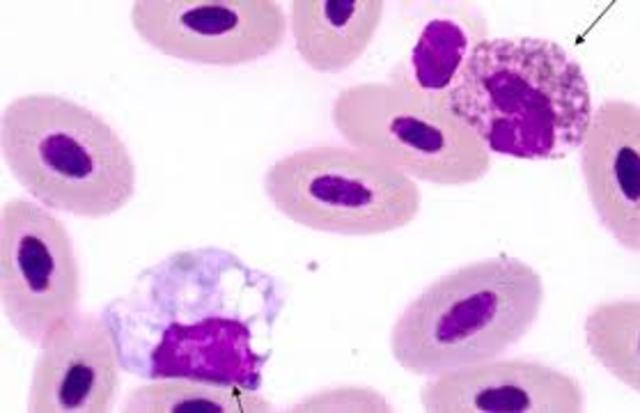
Addition to Glandular Fever

-
The infectious disease entitled, Mononucleosis started off as ‘Glandular Fever’ by a few German doctors. The name ‘Glandular Fever’ was created because of the swollen glands and lymph nodes for people who were going through this infection.
-
An mononucleosis outbreak in an Ohio community amoung several adults and children.
-
The name of "Infectious Mononucleosis" was used to describe 6 ill college students undertaken by lymphocytosis and atypical mononuclear cells in their blood.
-
Glandular Fever was later changed to “Infectious Mononucleosis” shorthand form “Mono” and the name was introduced by Thomas P. Sprunt and Frank A. Evans. At a point in time “Mononuclear leukocytes in reaction to acute infection(infectious mononucleosis)”, due to the causative organism, Epstein Barr Virus (EBV), it was yet to be understood.
-
Researchers unveil a more accurate method for diagnosing the virus
-
Further Paul and Burnell discovered a mysterious antibody by the name of Heterophil in Glandular Fever.
-
Micheal Anthony Epstein and Yvonne Barr were the two to establish, what is now called ‘Epstein Barr Virus’. They found the Epstein virus to be apart of the Herpes Virus.
-
The discovery that Epstien Barr Virus was what causes mononucleosis uncovered by accident. A lab technician was examining EBV and received the infection while on vacation. She experienced fever, sore throat, fatigue, and swollen lymph nodes. She was tested positive for Epstein Barr Virus.
-
At one point in time Only about 5% of adults in Western societies remain EBV uninfected. Meaning 95% of Western societies had EBV virus inside of their bodies.
-
After the discovery of Epstein-Barr Virus, it was discovered that the virus also attacked and immortalized B lymphocytes which is the target cell. B lymphocytes are used to secrete antibodies into body fluids.
-
Belgian researchers found a new compound that limited the number of patients with mono infections by EBV to 2% for the population who received the vaccine, in contrast to the 10% not treated.
-
The development of a vaccine against Epstein-Barr virus (EBV) has taken a step forward with the Canadian discovery of how EBV infection evades detection by the immune system.
Want to make a timeline like this?
Use Timetoast to turn dates, events, milestones, and phases into a clear visual timeline you can build and share. Timetoast is a timeline maker for work, school, research, and stories.